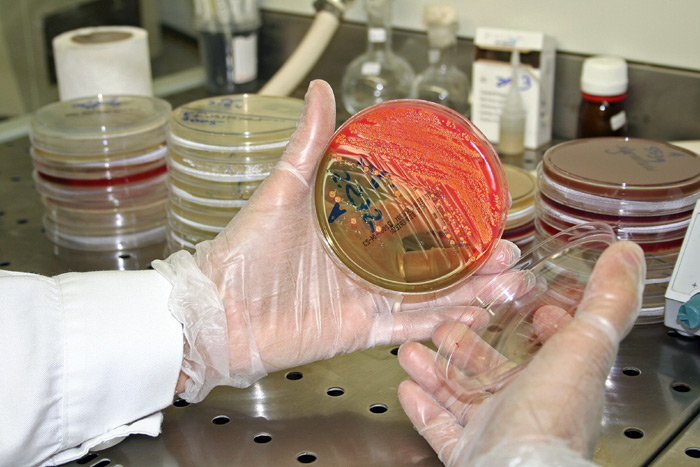

Vetëm pak muaj nga hapja e “bankës së fekaleve”, në Shtetet e Bashkuara të Amerikës është shënuar një bum dhurimesh.
Kjo bankë mbledh kampione jashtëqitjesh të dhuruara nga vullnetarë të ndryshëm, në kuadër të një projekti të njohur si baktero-terapia, ku ibjektivi i kësaj terapie është kurimi i infeksioneve të vështira.
Kjo bankë e krijuar në Boston, bazohet në dhurimin vullnetar, ndërsa kampionët e jashtëqitjeve transformohen më tej në ilaçe të vërteta, të cilat në qese sterile u dërgohen spitaleve të ndryshme në vend.
“Clostridium” është një bakter i cili jeton në aparatin tretës, por që në raste të veçanta shndërrohet në një infeksion vërtetë serioz, i cili çon drejt vdekjes.
Në Shtetet e Bashkuara të Amerikës çdo vit numërohen 1400 viktima nga ky bakter, i cili viteve të fundit është bërë tejet rezistent ndaj antibiotikëve.
Studimi i fundit i cili konfirmoi efikasitetin e baktero-terapisë për të luftuar infeksionet, u botua në vitin 2013 në revistën Neë england journal of medicine”./a.y/noa.al/
Bashkohu me kanalin e NOA WhatsApp për lajmet më të fundit direkt në celularin tënd







